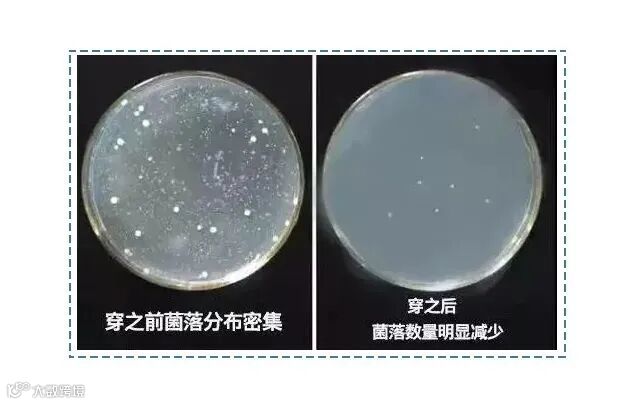

推荐理由:现在很多劣质内裤又硬又厚又紧,穿着不舒服还容易有异味。而这条120支冰丝抑菌男士内裤,吸湿又透气,不闷汗不捂汗,穿着运动非常舒服,爽到像裸穿!
天气一热,男人就变丑。
头发一沓,异常邋遢!出门十分,汗流一吨!
特别是下半身!
因为生理结构问题
男人的裆部汗腺非常发达

天气一热,玩命得冒汗
无论是出门还是久坐
内裤像八爪鱼一样粘在身上
瘙痒又黏糊,还不能在公共场合抠内裤
别提多难受!

身为男人,得体的裤装下
没有一条舒适的内裤
如同决赛圈没有子弹
在这炎热的夏天,选择一条透气性巨优的内裤
让你的宝贝时刻都能呼吸,才是关键!

穿着不舒服的内裤,不舒服是其次
致命的是它带来的影响
质量差的内裤,容易导致充血
红肿、炎症频发
那么,怎样一条内裤才能被称为“好内裤”呢?
结合自身体会
我认为一条好内裤需要具备以下三点:
01*透气性好*
02*吸湿性好*
03*质地舒适*

我一同事大热天30多度,天天都穿牛仔裤
难道他就不热吗?
一问才知道,他内藏乾坤
里面穿了一条能清凉到每一寸肌肤
而且丝滑透不粘身的冰丝凉感内裤

我问他是什么感觉,他很满意的说了一句
“像开启了一个新世界,天高任鸟飞”
今天就给大家种草这款
拯救男同胞们出“苦海”的好内裤
军武优选粉丝福利价69元/3条
点击下方图片即可选购
刚拿到手,第一感觉就是惊讶:
特别轻透柔滑,以前穿的那种跟这没法比

大热天30多度,天天都穿牛仔裤
下面像空调房一样,清凉到每一寸肌肤
而且穿着打球,上身大汗淋漓
下面依旧透爽不粘身

穿过的兄弟都一致好评,都说相见恨晚
以前真的苦了DD
优点①
蛋蛋的移动空调,穿上立降3°C-5°C
一到夏天,男人对内裤
最关注的无非就是2个字:凉快!
这款内裤有29000个微透气孔
看得见的加倍透气,内裤会呼吸
说的就是这种感觉!

薄度仅有1mm!
穿在身上,跟裸奔一样
没有任何束缚感和压迫感

具体有多薄?
透过内裤看视频,一点都不影响
画面感依然十分清晰

薄而不透,并不会有那种很娘炮的透光感
穿着就像给屁屁敷了一层面膜一样

穿着这样一条内裤,究竟有多凉爽?
我们来做个测试
把手同时放在冰丝内裤和普通内裤的上面:

咱们能清晰得看到,只过了短短的几秒钟
冰丝内裤(下图右)上
手掌的热度已经散得差不多了
而普通内裤(下图左)
还能看出较清晰的手掌心热度
基本没有散热功能,这夏天穿跟蒸笼一样

光散热怎么够,降温才是冰丝内裤的灵魂!
用吹风机分别给两条内裤的裆部吹热风10分钟后
分别记录在正常室温下10s,30s
1min三个时间段的散热对比:
自然散热10s对比:

自然散热30s对比:

28.8°C VS 33.2°C
自然散热1min对比:

24.2°C VS 29.0°C
穿上后比普通内裤降温4°C,比空调舒服多了!
那股凉意就像游泳时被水流包裹着
超级凉快舒服~

而且洗涤,揉搓,暴晒
都不会影响内裤的凉感

优点②
吸湿透气,时刻干爽透气状态
如此清凉的关键就在于它特殊的面料——锦纶冰丝

在成衣上采用冰丝面料其实早已见怪不怪!
早在日本,著名的时装设计大师山本耀司
就已经将这种面料融合到春夏季的设计当中

用冰丝做成的衣服一经推出就风靡日本
上架基本上就是疯抢的状态!
被评为日本夏季最畅销的衣物面料之一

这种面料不但降温散热快
而且它还具备比一般面料强的2倍以上的
导湿排汗性能!
内层吸汗吸湿,外层排湿导汗

吸湿排汗性能佳,我们从两个方面测试了一下
首先是裆部,水一滴上去,秒被吸收↓

内档吸湿性好,很大程度上避免
兄弟尿尿完没抖干净尿液,渗到外面裤子的尴尬
其次,其他部位3秒瞬吸,出汗再多也不黏腻

非常透气,从此告别闷热湿潮
时刻保持清爽不闷

一杯水倒下去,就像过滤一样,直接渗透了

即使是在闷热的夏季,也能瞬间吸湿
极速蒸发、速干、晾干的时间比纯棉品快3倍!
湿透的裤子自然风干,不到5分钟就干透

优点③
3A级抑菌99%,爱护你的健康
据微生物研究调查:
穿了一天的内裤会残留0.1g粪便
再加上男生尿后都是抖抖完事
没有擦拭的习惯
内裤里粪便、尿液混着汗水
简直就是细菌的温床
很多男人之痛就是这样日积月累而来

(高倍显微镜下霉菌滋生过程)
泌尿外科医生也指出
内裤最好是3-6个月换新一次

内裆加入了石墨烯抗菌技术
有效抑菌,将外来细菌杜绝在外

24小时自动抑菌杀菌
根源扼杀异味源头,呵护丁丁
获得国家检测报告抗菌力98%
达3A级抑菌效果,水洗50次后功效不减

优点④
一体式设计,舒适裸穿体验
如果你仔细看,会发现这条没有一条缝边
都是一体成型的
那是因为由纱线立体编织成型
整条内裤的弹力都舒适、均匀
只有意大利进口的无缝织机能做出来
对工艺要求非常高

因此,它的弹性比普通棉内裤都要大得多
不管你是有啤酒肚的爷们儿,还是爱运动的型男
穿上裸感无束缚,不紧绷,不勒腰
不勒腿,拉扯不变形

再者,一体成型意味着裤腰、裤身
裤脚、内档都没有车缝线
穿着无感舒服的同时也减轻了内裤的重量

这款面膜冰丝内裤只有9g
比一枚1元硬币还轻
0.01mm薄+9g轻=真正的“裸感体验”

出厂前还经过2小时不间断摩擦测试
经久耐穿,不起球

制作过程有一道预先缩水工序
保证内裤洗完不缩水,不会越洗越小

更不用担心像10元3条一样的劣质内裤
那样会掉色,有荧光剂
质量可靠,不含荧光剂
为咱们的身体创造安全环境

双层面料+U凸囊袋设计
能装下更大,视觉上更自信
充足的呼吸空间
又能很好地承托摆正位置,更显大器🍆


军武优选粉丝福利价69元/3条
点击下方图片即可选购


扫码添加军武推荐官
军迷喜欢的这里都有↓






